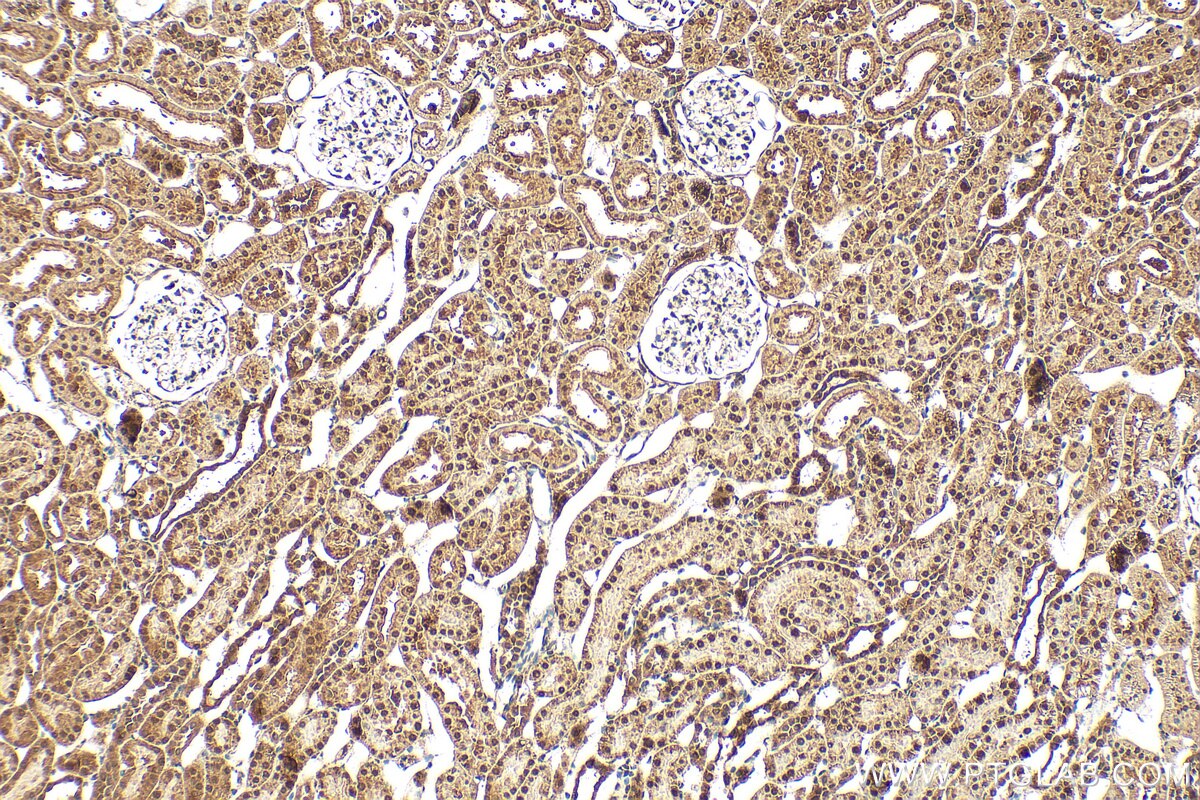
Immunohistochemistry (IHC) staining of rat kidney tissue using STOX2 Polyclonal antibody (32724-1-AP)
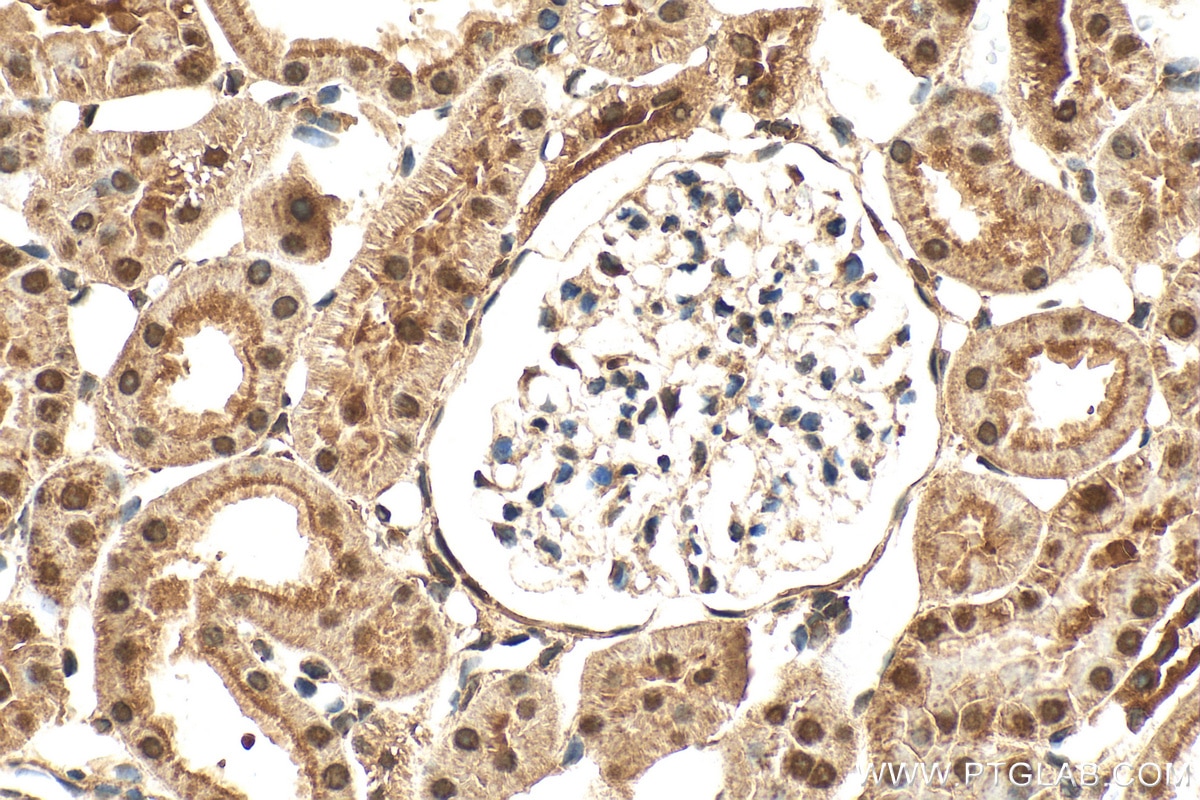
Immunohistochemistry (IHC) staining of rat kidney tissue using STOX2 Polyclonal antibody (32724-1-AP)

Tested Applications
| Positive WB detected in | mouse kidney tissue |
| Positive IHC detected in | rat kidney tissue Note: suggested antigen retrieval with TE buffer pH 9.0; (*) Alternatively, antigen retrieval may be performed with citrate buffer pH 6.0 |
Recommended dilution
| Application | Dilution |
|---|---|
| Western Blot (WB) | WB : 1:1000-1:4000 |
| Immunohistochemistry (IHC) | IHC : 1:50-1:500 |
| It is recommended that this reagent should be titrated in each testing system to obtain optimal results. | |
| Sample-dependent, Check data in validation data gallery. | |
Product Information
32724-1-AP targets STOX2 in WB, IHC, ELISA applications and shows reactivity with human, mouse samples.
| Tested Reactivity | human, mouse |
| Host / Isotype | Rabbit / IgG |
| Class | Polyclonal |
| Type | Antibody |
| Immunogen |
CatNo: Ag37972 Product name: Recombinant human STOX2 protein Source: e coli.-derived, PGEX-4T Tag: GST Domain: 297-630 aa of BC146754 Sequence: LRDEDTPATIPREVEMEIIRRINPDLTVENVMRHTALMKKLEEEKAQRSKAGSSAHHSGRSKKSRTHRKSHGKSRSHSKTRVSKGDPSDGSHLDIPAEREYDFCDPLTRVPREGCFIIEHKGDNFIMHSNTNVLESHFPMTPEWDVSGELAKRRTEMPFPEPSRGSSHSKVHRSHSHTQDRRSRNERSNKAKERSRSMDNSKGPLGASSLGTPEDLAEGCSQDDQTPSQSYIDDSTLRPAQTVSLQRAHISSTSYKEVCIPEIVSGSKEPSSACSLLEPGKPPESLPSYGELNSCPTKTATDDYFQCNTSSETVLTAPSPLGKNKEDHDTLTLA Predict reactive species |
| Full Name | storkhead box 2 |
| Calculated Molecular Weight | 926 aa, 103 kDa |
| Observed Molecular Weight | 103 kDa |
| GenBank Accession Number | BC146754 |
| Gene Symbol | STOX2 |
| Gene ID (NCBI) | 56977 |
| Conjugate | Unconjugated |
| Form | Liquid |
| Purification Method | Antigen affinity Purification |
| UNIPROT ID | Q9P2F5 |
| Storage Buffer | PBS with 0.02% sodium azide and 50% glycerol, pH 7.3. |
| Storage Conditions | Store at -20°C. Stable for one year after shipment. Aliquoting is unnecessary for -20oC storage. 20ul sizes contain 0.1% BSA. |
Protocols
| Product Specific Protocols | |
|---|---|
| IHC protocol for STOX2 antibody 32724-1-AP | Download protocol |
| WB protocol for STOX2 antibody 32724-1-AP | Download protocol |
| Standard Protocols | |
|---|---|
| Click here to view our Standard Protocols |